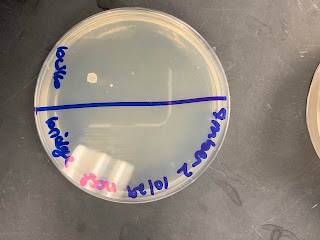

It is so great that the semester is ending. It was fun but majorly stressful. I hope you guys had a great semester and have your projects going well too.
Sadly I was not able to complete my project in time to get to the point of identifying each bacteria. I do believe that I have more data since last time but if only I did not run out of time. But at least the three test tubes that didn't grow previously finally grew on blood agar.
Hopefully the samples will not die in the fridge over the break. But I feel like each semester is a learning process on how to build a better project. I am actually excited for the Metro Tech presentations and I can't wait to see yours too.
I had a great time with the rest of you guys this semester, I'll miss you guys. Have a great break!